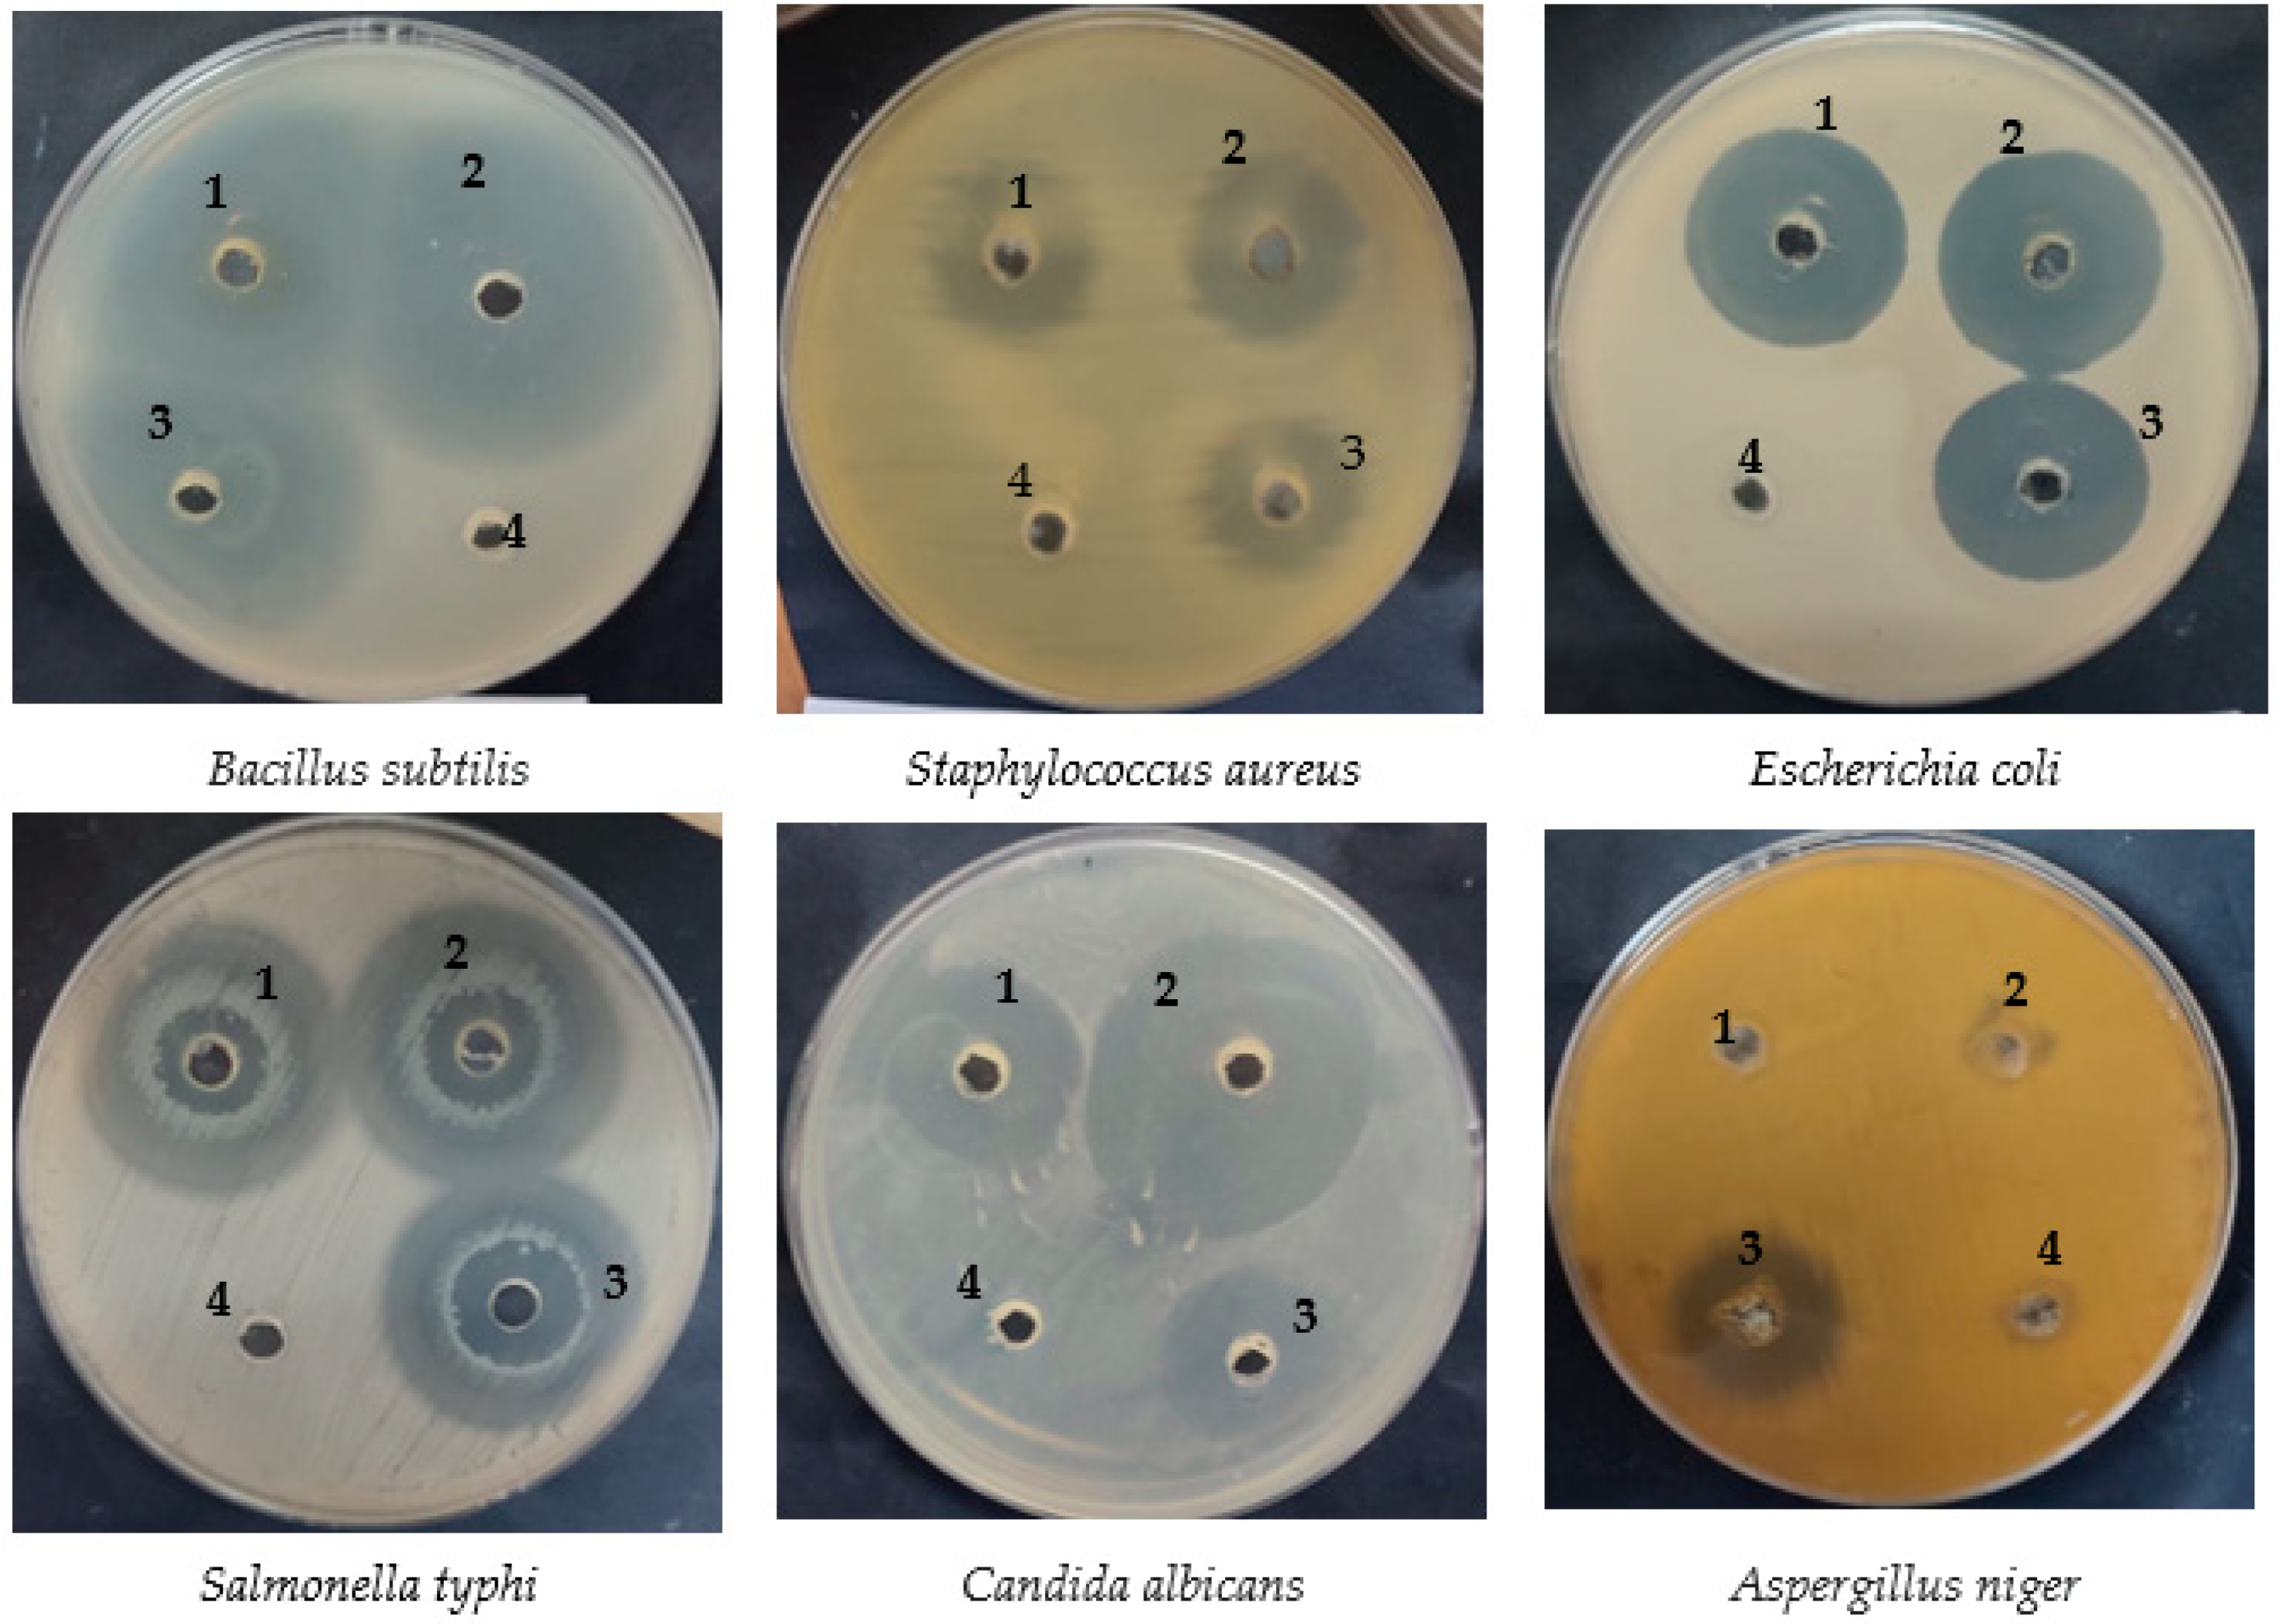
Pharmaceuticals 16 01731 g002

Antimicrobial, Anticancer, and Antioxidant Activities of Maize and Clover Pollen Grains Extracts: A Comparative Study with Phytochemical Characterizations
Abstract
:1. Introduction
2. Results and Discussion
2.1. Phytoconstituents Characterizations
2.2. Antimicrobial Activity of Maize and Clover Pollen Grains Extract
2.3. Antioxidant Activity of Maize and Clover Pollen Grains Extract
2.4. Anticancer Activity of Pollen Grains
3. Materials and Methods
3.1. Pollen Grains Source and Extraction
3.2. Assessment of Phenolic and Flavonoid Constituents of Pollen Grains by HPLC
3.3. Tested Microorganisms and Cancer Cell Line
3.4. Antimicrobial Activity of Pollen Grains Extract
3.5. Minimal Bactericidal Concentration (MBC) and Minimum Inhibitory Concentration (MIC) of Pollen Grains Extract
3.6. Ultrastructure of E. coli
3.7. Antioxidant Activity of Pollen Grains Extract
3.8. Anticancer Activity of Pollen Grains Extract and Morphological Characteristics of Cancer Cells
3.9. Statistical Analysis
4. Conclusions
Supplementary Materials
Author Contributions
Funding
Institutional Review Board Statement
Informed Consent Statement
Data Availability Statement
Acknowledgments
Conflicts of Interest
References
- Kao, Y.T.; Lu, M.J.; Chen, C. Preliminary analyses of phenolic compounds and antioxidant activities in tea pollen extracts. J. Food Drug Anal. 2011, 19, 470–477. [Google Scholar] [CrossRef]
- Avşar, C.; Özler, H.; Berber, I.; Civek, S. Phenolic composition, antimicrobial and antioxidant activity of Castanea sativa Mill. pollen grains from Black Sea region of Turkey. Int. Food Res. J. 2016, 23, 1711–1716. [Google Scholar]
- Daoud, A.; Malika, D.; Bakari, S.; Hfaiedh, N.; Mnafgui, K.; Kadri, A.; Gharsallah, N. Assessment of polyphenol composition, antioxidant and antimicrobial properties of various extracts of Date Palm Pollen (DPP) from two Tunisian cultivars. Arab. J. Chem. 2019, 12, 3075–3086. [Google Scholar] [CrossRef]
- Almaraz-Abarca, N.; da Graça Campos, M.; Ávila-Reyes, J.A.; Naranjo-Jiménez, N.; Herrera Corral, J.; González-Valdez, L.S. Antioxidant activity of polyphenolic extract of monofloral honeybee-collected pollen from mesquite (Prosopis juliflora, Leguminosae). J. Food Compos. Anal. 2007, 20, 119–124. [Google Scholar] [CrossRef]
- Uzbekova, D.M.V.; Khvoynitskaya, L.; Slepnev, A. Evaluation of bee collected pollen influence on lipid peroxidation, antioxidant system and liver function in old animals. Hepatology 2003, 38, 203–208. [Google Scholar] [CrossRef]
- Choi, E.M. Antinociceptive and antiinflammatory activities of pine (Pinus densiflora) pollen extract. Phytother. Res. 2007, 21, 471–475. [Google Scholar] [CrossRef]
- LeBlanc, B.W.; Davis, O.K.; Boue, S.; DeLucca, A.; Deeby, T. Antioxidant activity of Sonoran Desert bee pollen. Food Chem. 2009, 115, 1299–1305. [Google Scholar] [CrossRef]
- Abdelghany, T.M.; Yahya, R.; Bakri, M.M.; Ganash, M.; Amin, B.H.; Qanash, H. Effect of Thevetia peruviana seeds extract for microbial pathogens and cancer control. Int. J. Pharmacol. 2021, 17, 643–655. [Google Scholar] [CrossRef]
- Al-Rajhi, A.M.H.; Qanash, H.; Almashjary, M.N.; Hazzazi, M.S.; Felemban, H.R.; Abdelghany, T.M. Anti-Helicobacter pylori, Antioxidant, Antidiabetic, and Anti-Alzheimer’s Activities of Laurel Leaf Extract Treated by Moist Heat and Molecular Docking of Its Flavonoid Constituent, Naringenin, against Acetylcholinesterase and Butyrylcholinesterase. Life 2023, 13, 1512. [Google Scholar]
- Qanash, H.; Bazaid, A.S.; Aldarhami, A.; Alharbi, B.; Almashjary, M.N.; Hazzazi, M.S.; Felemban, H.R.; Abdelghany, T.M. Phytochemical Characterization and Efficacy of Artemisia judaica Extract Loaded Chitosan Nanoparticles as Inhibitors of Cancer Proliferation and Microbial Growth. Polymers 2023, 15, 391. [Google Scholar] [CrossRef]
- Velásquez, P.; Rodriguez, K.; Retamal, M.; Giordano Villatoro, A.; Valenzuela Roediger, L.M.; Montenegro Rizzardini, G. Relation between composition, antioxidant and antibacterial activities and botanical origin of multi-floral bee pollen. J. Appl. Bot. Food Qual. 2017, 90, 306–314. [Google Scholar] [CrossRef]
- Kaur, R.; Nagpal, A.; Katnoria, J.K. Exploration of antitumor properties of pollen grains of plant species belonging to fabaceae family. J. Pharm. Sci. Res. 2015, 7, 127–129. [Google Scholar]
- Han, L.; Liu, X.; Yang, N.; Li, J.; Cai, B.; Cheng, S. Simultaneous chromatographic fingerprinting and quantitative analysis of flavonoids in Pollen Typhae by high-performance capillary electrophoresis. Acta Pharm. Sin. B 2012, 2, 602–609. [Google Scholar] [CrossRef]
- Chantarudee, A.; Phuwapraisirisan, P.; Kimura, K.; Okuyama, M.; Mori, H.; Kimura, A.; Chanchao, C. Chemical constituents and free radical scavenging activity of corn pollen collected from Apis mellifera hives compared to floral corn pollen at Nan, Thailand. BMC Complement. Altern. Med. 2012, 12, 45. [Google Scholar] [CrossRef] [PubMed]
- Moniruzzaman, M.; Khalil, M.I.; Sulaiman, S.A.; Gan, S.H. Physicochemical and antioxidant properties of Malaysian honeys produced by Apis cerana, Apis dorsata and Apis mellifera. BMC Complement. Altern. Med. 2013, 13, 43. [Google Scholar] [CrossRef] [PubMed]
- Mărgăoan, R.; Stranț, M.; Varadi, A.; Topal, E.; Yücel, B.; Cornea-Cipcigan, M.; Campos, M.G.; Vodnar, D.C. Bee Collected Pollen and Bee Bread: Bioactive Constituents and Health Benefits. Antioxidants 2019, 8, 568. [Google Scholar] [CrossRef] [PubMed]
- Premratanachai, P.; Chanchao, C. Review of the anticancer activities of bee products. Asian Pac. J. Trop. Biomed. 2014, 4, 337–344. [Google Scholar] [CrossRef] [PubMed]
- Elsayed, N.; El-Din, H.S.; Altemimi, A.B.; Ahmed, H.Y.; Pratap-Singh, A.; Abedelmaksoud, T.G. In Vitro Antimicrobial, Antioxidant and Anticancer Activities of Egyptian Citrus Beebread. Molecules 2021, 26, 2433. [Google Scholar] [CrossRef]
- Bakour, M.; Laaroussi, H.; Ousaaid, D.; Oumokhtar, B.; Lyoussi, B. Antioxidant and Antibacterial Effects of Pollen Extracts on Human Multidrug-Resistant Pathogenic Bacteria. J. Food Qual. 2021, 2021, 5560182. [Google Scholar] [CrossRef]
- Žilić, S.; Vančetović, J.; Janković, M.; Maksimović, V. Chemical composition, bioactive compounds, antioxidant capacity and stability of floral maize (Zea mays L.) pollen. J. Funct. Foods 2014, 10, 65–74. [Google Scholar] [CrossRef]
- Bakour, M.; Campos, M.d.G.; Imtara, H.; Lyoussi, B. Antioxidant content and identification of phenolic/flavonoid compounds in the pollen of fourteen plants using HPLC-DAD. J. Apic. Res. 2020, 59, 35–41. [Google Scholar] [CrossRef]
- Sarić, A.; Balog, T.; Sobocanec, S.; Kusić, B.; Sverko, V.; Rusak, G.; Likić, S.; Bubalo, D.; Pinto, B.; Reali, D.; et al. Antioxidant effects of flavonoid from Croatian Cystus incanus L. rich bee pollen. Food Chem. Toxicol. 2009, 47, 547–554. [Google Scholar] [CrossRef]
- Abdel-Rasheed, K.G.; Moustafa, Y.M.; Hassan, E.A.; Abdel-Ati, Y.Y.; Gadel-Hak, S.-E.H. Honeybee Collected Pollen as Antibiotics to Control American Foul Brood Disease, at Giza Governorate. Egypt. J. Agric. Res. 2017, 95, 1551–1563. [Google Scholar] [CrossRef]
- Khider, M.; Elbanna, K.; Mahmoud, A.; Owayss, A.A. Egyptian honeybee pollen as antimicrobial, antioxidant agents, and dietary food supplements. Food Sci. Biotechnol. 2013, 22, 1–9. [Google Scholar] [CrossRef]
- Rocha, M.F.G.; Sales, J.A.; da Rocha, M.G.; Galdino, L.M.; de Aguiar, L.; Pereira-Neto, W.A.; de Aguiar Cordeiro, R.; Castelo-Branco, D.; Sidrim, J.J.C.; Brilhante, R.S.N. Antifungal effects of the flavonoids kaempferol and quercetin: A possible alternative for the control of fungal biofilms. Biofouling 2019, 35, 320–328. [Google Scholar] [CrossRef]
- Bashiri, Z.; Yousefi, M.; Royce, S.G.; Fereidouni, M. Antibacterial activity of aqueous and lipid extracts of five common allergenic pollens. J. Med. Plants 2022, 21, 11–18. [Google Scholar] [CrossRef]
- Kuete, V. Potential of Cameroonian plants and derived products against microbial infections: A review. Planta Med. 2010, 76, 1479–1491. [Google Scholar] [CrossRef]
- Ganash, M. Genotoxic and Antitumor Activity of Pollen Grains against Prostate Cancer Cell Line. Int. J. Pharma Bio Sci. 2021, 11, 36–46. [Google Scholar] [CrossRef]
- Leja, M.; Mareczek, A.; Wyżgolik, G.; Klepacz-Baniak, J.; Czekońska, K. Antioxidative properties of bee pollen in selected plant species. Food Chem. 2007, 100, 237–240. [Google Scholar] [CrossRef]
- Mărghitaş, L.A.; Stanciu, O.G.; Dezmirean, D.S.; Bobiş, O.; Popescu, O.; Bogdanov, S.; Campos, M.G. In vitro antioxidant capacity of honeybee-collected pollen of selected floral origin harvested from Romania. Food Chem. 2009, 115, 878–883. [Google Scholar] [CrossRef]
- Bujang, J.S.; Zakaria, M.H.; Ramaiya, S.D. Chemical constituents and phytochemical properties of floral maize pollen. PLoS ONE 2021, 16, e0247327. [Google Scholar] [CrossRef]
- Gercek, Y.C.; Celik, S.; Bayram, S. Screening of Plant Pollen Sources, Polyphenolic Compounds, Fatty Acids and Antioxidant/Antimicrobial Activity from Bee Pollen. Molecules 2021, 27, 117. [Google Scholar] [CrossRef] [PubMed]
- Wang, B.; Diao, Q.; Zhang, Z.; Liu, Y.; Gao, Q.; Zhou, Y.; Li, S. Antitumor activity of bee pollen polysaccharides from Rosa rugosa. Mol. Med. Rep. 2013, 7, 1555–1558. [Google Scholar] [CrossRef] [PubMed]
- Roszkowski, S. Application of Polyphenols and Flavonoids in Oncological Therapy. Molecules 2023, 28, 4080. [Google Scholar] [CrossRef] [PubMed]
- Peterson, L.R.; Collins, S.M. Bactericidal testing for infectious disease therapy: The why and how to measure if we kill the bugs. Clin. Microbiol. Newsl. 2000, 22, 153–157. [Google Scholar] [CrossRef]
- Bazaid, A.S.; Alsolami, A.; Patel, M.; Khateb, A.M.; Aldarhami, A.; Snoussi, M.; Almusheet, S.M.; Qanash, H. Antibiofilm, Antimicrobial, Anti-Quorum Sensing, and Antioxidant Activities of Saudi Sidr Honey: In Vitro and Molecular Docking Studies. Pharmaceutics 2023, 15, 2177. [Google Scholar] [CrossRef] [PubMed]
- Abdelghany, T.M.; Bakri, M.M.; Al-Rajhi, A.M.H.; Al Abboud, M.A.; Alawlaqi, M.M.; Shater, A.R.M. Impact of copper and its nanoparticles on growth, ultrastructure, and laccase production of Aspergillus niger using corn cobs wastes. BioResources 2020, 15, 3289–3306. [Google Scholar] [CrossRef]
- Al-Rajhi, A.M.H.; Yahya, R.; Abdelghany, T.M.; Fareid, M.A.; Mohamed, A.M.; Amin, B.H.; Masrahi, A.S. Anticancer, Anticoagulant, Antioxidant and Antimicrobial Activities of Thevetia peruviana Latex with Molecular Docking of Antimicrobial and Anticancer Activities. Molecules 2022, 27, 3165. [Google Scholar] [CrossRef] [PubMed]
- Qanash, H.A.; Alotaibi, K.; Bazaid, A.S.; Ganash, M.; Saeedi, N.H.; Ghany, T.A. Effectiveness of Oil-based Nanoemulsions With Molecular Docking of its Antimicrobial Potential. BioResources 2023, 18, 1554–1576. [Google Scholar] [CrossRef]
- Qanash, H.; Bazaid, A.S.; Binsaleh, N.K.; Patel, M.; Althomali, O.W.; Sheeha, B.B. In Vitro Antiproliferative Apoptosis Induction and Cell Cycle Arrest Potential of Saudi Sidr Honey against Colorectal Cancer. Nutrients 2023, 15, 3448. [Google Scholar] [CrossRef]

| Compound | Pollen Grains Extract of Maize | Pollen Grains Extract of Clover | ||||||
|---|---|---|---|---|---|---|---|---|
| Retention Time | Area | Area (%) | Conc. (µg/mL) | Retention Time | Area | Area (%) | Conc. (µg/mL) | |
| Gallic acid | 3.544 | 22.87 | 2.0647 | 100.21 | 3.542 | 22.81 | 0.7373 | 99.97 |
| Chlorogenic acid | 4.300 | 15.59 | 1.4080 | 107.04 | 4.301 | 12.87 | 0.4159 | 88.33 |
| Catechin | 4.597 | 3.56 | 0.3218 | 41.14 | 4.714 | 4.03 | 0.1304 | 46.58 |
| Methyl gallate | 5.580 | 404.47 | 36.5194 | 1056.57 | 5.589 | 38.86 | 1.2556 | 101.50 |
| Caffeic acid | 6.087 | 17.13 | 1.5468 | 70.61 | 6.094 | 112.76 | 3.6439 | 464.73 |
| Syringic acid | 6.440 | 0.00 | 0.00 | 0.00 | 6.440 | 0.00 | 0.00 | 0.00 |
| Pyro catechol | 6.572 | 157.19 | 14.1924 | 1145.56 | 6.568 | 18.73 | 0.6052 | 136.48 |
| Rutin | 6.917 | 8.44 | 0.7624 | 68.41 | 6.925 | 0.00 | 0.00 | 0.00 |
| Ellagic acid | 7.531 | 1.45 | 0.1311 | 6.26 | 7.100 | 8.83 | 0.2854 | 38.09 |
| Coumaric acid | 8.299 | 94.09 | 8.4950 | 175.21 | 8.299 | 7.67 | 0.2479 | 14.29 |
| Vanillin | 8.942 | 26.10 | 2.3567 | 49.82 | 8.956 | 2.32 | 0.0748 | 4.42 |
| Ferulic acid | 9.802 | 1.92 | 0.1734 | 5.88 | 9.960 | 17.63 | 0.5698 | 53.98 |
| Naringenin | 10.590 | 12.37 | 1.1170 | 59.60 | 10.580 | 0.84 | 0.0273 | 4.07 |
| Rosmarinic acid | 11.723 | 1.75 | 0.1583 | 9.69 | 12.181 | 23.82 | 0.7697 | 131.66 |
| Daidzein | 16.203 | 2.60 | 0.2348 | 7.65 | 16.025 | 3.66 | 0.1183 | 10.77 |
| Quercetin | 17.276 | 8.63 | 0.7796 | 53.90 | 17.272 | 62.97 | 2.0347 | 393.05 |
| Cinnamic acid | 19.541 | 15.42 | 1.3923 | 14.38 | 19.184 | 19.26 | 0.6224 | 17.97 |
| Kaempferol | 20.559 | 6.59 | 0.5950 | 21.84 | 20.814 | 117.93 | 3.8108 | 390.93 |
| Hesperetin | 21.181 | 5.39 | 5.38755 | 13.98 | 21.181 | 6.16 | 0.1990 | 15.97 |
| Tested Microorganisms | Mean Inhibition Zone (mm) | p Value | MIC (µg/mL) | p Value | MBC (µg/mL) | p Value | MBC/MIC Index | p Value | ||||||
|---|---|---|---|---|---|---|---|---|---|---|---|---|---|---|
| Maize | Clover | +ve C * | -ve C * | Maize | Clover | Maize | Clover | Maize | Clover | |||||
| Bacillus subtilis | 42 ± 0.4 a | 39 ± 0.3 b | 33 ± 0.1 c | 0.0 | 0.000 | 3.9 ± 0.33 a | 3.9 ± 0.25 a | 1.00 | 7.9 ± 0.35 a | 3.9 ± 0.2 b | 0.00 | 2.02 a | 1.0 b | 0.00 |
| Staphylococcus aureus | 19 ± 0.3 b | 22 ± 0.2 a | 16 ± 0.2 c | 0.0 | 0.001 | 125 ± 4.0 a | 62.5 ± 1.00 b | 0.00 | 125 ± 1.53 a | 125 ± 3 a | 1.00 | 1.0 b | 2.5 a | 0.00 |
| Escherichia coli | 15 ± 0.4 b | 18 ± 0.1 a | 18 ± 0.3 a | 0.0 | 0.016 | 250 ± 3.0 a | 62.5 ± 0.07 b | 0.00 | 500 ± 3.0 a | 125 ± 4 b | 0.000 | 2.0 a | 2.5 a | 0.288 |
| Salmonella typhi | 27 ± 0.1 ab | 29 ± 0.3 a | 25 ± 0.1 b | 0.0 | 0.125 | 31.25 ± 1.33 a | 31.25 ± 0.5 a | 1.00 | 31.25 ± 1.53 b | 62.5 ± 1 a | 0.00 | 1.0 b | 2.0 a | 0.00 |
| Candida albicans | 22 ± 0.4 b | 42 ± 0.4 a | 21 ± 0.3 b | 0.0 | 0.000 | 15.62 ± 0.35 a | 1.97 ± 0.04 b | 0.00 | 15.62 ± 1.32 a | 3.97 ± 0.2 b | 0.002 | 1.0 b | 2.01 a | 0.00 |
| Aspergillus niger | NA | NA | 20 ± 0.4 | 0.0 | 0.000 | - | - | - | - | - | - | |||
| Concentration (µg/mL) | DPPH Scavenging (%) | p Value | ||
|---|---|---|---|---|
| Maize | Clover | Ascorbic Acid | ||
| 1000 | 85.6 ± 0.05 c | 92.1 ± 0.01 b | 99.2 ± 0.02 a | 0.000 |
| 500 | 74.1 ± 0.17 c | 84.4 ± 0.02 b | 96.1 ± 0.031 a | 0.002 |
| 250 | 66.2 ± 0.24 c | 76.2 ± 0.04 b | 94.6 ± 0.14 a | 0.000 |
| 125 | 58.5 ± 0.16 c | 68.1 ± 003 b | 91.8 ± 0.25 a | 0.000 |
| 62.50 | 51.3 ± 0.32 c | 61.4 ± 0.05 b | 84.3 ± 0.41 a | 0.001 |
| 31.25 | 43.3 ± 0.21 c | 53.9 ± 0.15 b | 76.2 ± 0.08 a | 0.005 |
| 15.63 | 35.8 ± 0.45 c | 46.3 ± 0.24 b | 67.7 ± 0.24 a | 0004 |
| 7.81 | 28.2 ± 0.21 c | 38.4 ± 0.18 b | 60.4 ± 0.21 a | 0.003 |
| 3.90 | 20.4 ± 0.32 c | 30.7 ± 0.06 b | 52.2 ± 0.41 a | 0.005 |
| 1.95 | 12.1 ± 0.15 c | 24.1 ± 0.09 b | 43.6 ± 0.14 a | 0.000 |
| 0.0 | 0.0 | 0.0 | 0.0 | |
| IC50 | 54.85 ± 0.21 a µg/mL | 22.18 ± 0.21 b µg/mL | 2.51 ± 0.24 c µg/mL | 0.000 |
| Concentration (µg/mL) | Cytotoxicity (%) | p Value | |
|---|---|---|---|
| Maize | Clover | ||
| 1000 | 97.57 ± 0.24 a | 97.53 ± 0.21 a | 1.00 |
| 500 | 97.61 ± 0.16 a | 96.53 ± 0.02 a | 0.288 |
| 250 | 94.92 ± 0.08 a | 95.05 ± 0.15 a | 0.168 |
| 125 | 81.99 ± 0.07 a | 76.82 ± 0.65 b | 0.038 |
| 62.50 | 60.81 ± 0.14 a | 55.38 ± 0.57 b | 0.028 |
| 31.25 | 19.84 ± 0.35 a | 13.06 ± 0.38 b | 0.021 |
| 0.0 | 0.0 | 0.0 | - |
| IC50 (µg/mL) | 67.02 ± 1.37 b | 75.03 ± 1.02 a | 0.004 |
Disclaimer/Publisher’s Note: The statements, opinions and data contained in all publications are solely those of the individual author(s) and contributor(s) and not of MDPI and/or the editor(s). MDPI and/or the editor(s) disclaim responsibility for any injury to people or property resulting from any ideas, methods, instructions or products referred to in the content. |
© 2023 by the authors. Licensee MDPI, Basel, Switzerland. This article is an open access article distributed under the terms and conditions of the Creative Commons Attribution (CC BY) license (https://creativecommons.org/licenses/by/4.0/).
Share and Cite
Barnawi, H.; Qanash, H.; Aldarhami, A.; Alsaif, G.; Alharbi, B.; Almashjary, M.N.; Almotiri, A.; Bazaid, A.S. Antimicrobial, Anticancer, and Antioxidant Activities of Maize and Clover Pollen Grains Extracts: A Comparative Study with Phytochemical Characterizations. Pharmaceuticals 2023, 16, 1731. https://doi.org/10.3390/ph16121731
Barnawi H, Qanash H, Aldarhami A, Alsaif G, Alharbi B, Almashjary MN, Almotiri A, Bazaid AS. Antimicrobial, Anticancer, and Antioxidant Activities of Maize and Clover Pollen Grains Extracts: A Comparative Study with Phytochemical Characterizations. Pharmaceuticals. 2023; 16(12):1731. https://doi.org/10.3390/ph16121731
Chicago/Turabian StyleBarnawi, Heba, Husam Qanash, Abdu Aldarhami, Ghaida Alsaif, Bandar Alharbi, Majed N. Almashjary, Alhomidi Almotiri, and Abdulrahman S. Bazaid. 2023. "Antimicrobial, Anticancer, and Antioxidant Activities of Maize and Clover Pollen Grains Extracts: A Comparative Study with Phytochemical Characterizations" Pharmaceuticals 16, no. 12: 1731. https://doi.org/10.3390/ph16121731
APA StyleBarnawi, H., Qanash, H., Aldarhami, A., Alsaif, G., Alharbi, B., Almashjary, M. N., Almotiri, A., & Bazaid, A. S. (2023). Antimicrobial, Anticancer, and Antioxidant Activities of Maize and Clover Pollen Grains Extracts: A Comparative Study with Phytochemical Characterizations. Pharmaceuticals, 16(12), 1731. https://doi.org/10.3390/ph16121731










